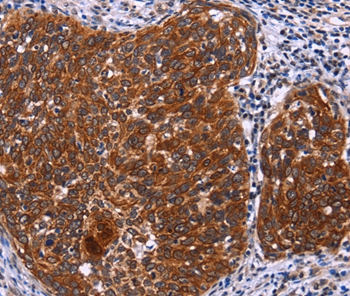

Search results: USP2
Product group Antibodies
USP2 AntibodyCSB-PA025710ESR1HU
ApplicationsELISA, ImmunoHistoChemistry
ReactivityHuman
TargetUSP2
- SizePrice
Product group Antibodies
USP2 AntibodyCSB-PA025710GA01HU
ApplicationsWestern Blot, ELISA, ImmunoHistoChemistry
ReactivityHuman, Mouse
TargetUSP2
- SizePrice
Product group Antibodies
USP2 AntibodyCSB-PA025710LA01HU
ApplicationsImmunoFluorescence, ELISA
ReactivityHuman
TargetUSP2
- SizePrice
Product group Antibodies
USP2 AntibodyCSB-PA155084
ApplicationsELISA, ImmunoHistoChemistry
ReactivityHuman, Mouse, Rat
TargetUSP2
- SizePrice
Product group Antibodies
Usp2 AntibodyCSB-PA877028XA01DLU
ApplicationsWestern Blot, ELISA
ReactivityDrosophila
TargetUsp2
- SizePrice
Product group Antibodies
USP2 AntibodyCSB-PA673833
ApplicationsELISA, ImmunoHistoChemistry
ReactivityHuman, Mouse, Rat
TargetUSP2
- SizePrice
Product group Antibodies

USP2 Monoclonal AntibodyBSM-51636M
ApplicationsWestern Blot
ReactivityHuman, Monkey
TargetUSP2
- SizePrice
Product group Antibodies
Anti-USP2 AntibodyA46762
ApplicationsImmunoHistoChemistry
ReactivityHuman
- SizePrice
Product group Antibodies
Anti-USP2 AntibodyM04288
ApplicationsWestern Blot
ReactivityHuman, Monkey
TargetUSP2
- SizePrice
Didn't find what you were looking for?
Search through our product groups to find the right product
Back to overview